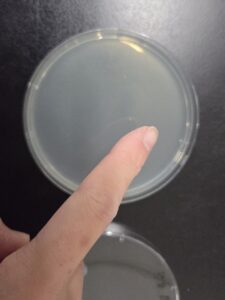
自分の手
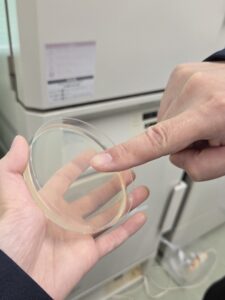
hさんの手
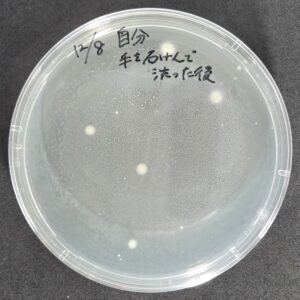
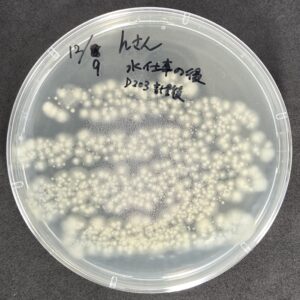
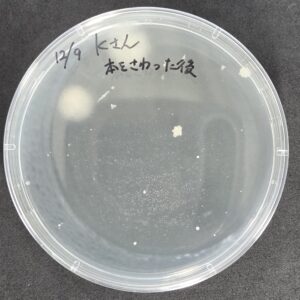
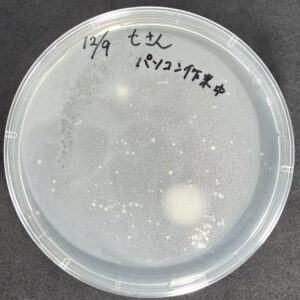
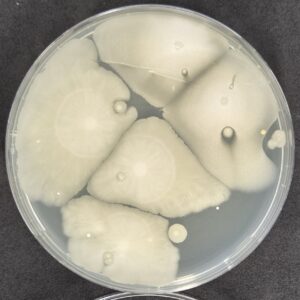
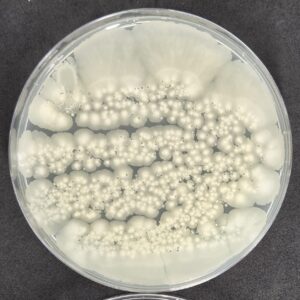
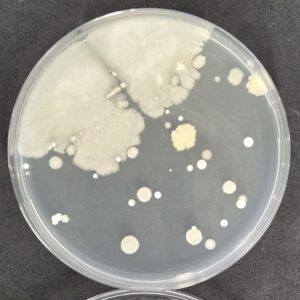
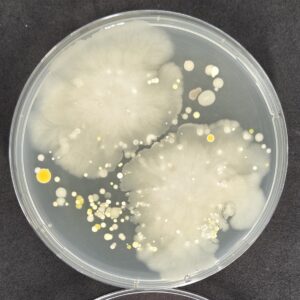
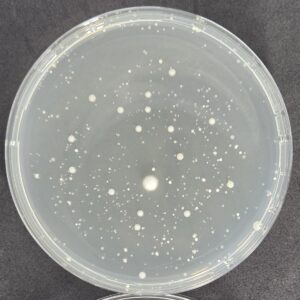

【検証】人の手には菌がいっぱい!口をつけた飲み物には菌がいっぱい!
こんにちは、ブログ投稿四回目のにゃべです!
今回のブログでは、身近に潜む菌のお話をしようと思います。
「身の回りには目には見えないけど沢山の菌がいるんだよ」
こんな感じのフレーズ、皆さんもどこかで一度は聞いたことがあるかと思います。
でも、実際本当にいるの?どのくらいいるの?どんな菌がいるの?と謎だらけですよね。
そ・こ・で!!!
身の回りにはどんな菌がどれくらいいるのか、実際に検証してみました!
今回の検証では、
- 人の手にはどんな菌がどれくらいいるのか?
- ペットボトルに口をつけた後、菌が増えるのか?
の2つについて調べてみました。
では、1つずつ詳しく見ていきましょう!
1. 人の手にはどんな菌がどれくらいいるのか?
ビッグバイオでお仕事中の社員さんたちに協力していただき、
私含め4人の手にどれくらい菌がいるのか調査しました。
方法は、寒天培地(※)の上を指でなぞるだけ!
※寒天培地とは…菌のエサとなる栄養分が豊富に含まれた液を寒天に固めたもの
自分の手
hさんの手

kさんの手

tさんの手
皆さんお仕事中だったので、色んな作業をした後の手で実験しました!
自分:石鹸で手を洗った後(in 研究室)
hさん:水を使った後(in 研究室)
kさん:本を触った後(in 研究室)
tさん:パソコン作業の後(in 事務所)
さあ、準備は整いました!
あとは30℃に設定した機械の中で菌を培養していきますよ~🦠
【培養1日後の様子】
自分1日培養
hさん1日培養
kさん1日培養
tさん1日培養
何やら白色の点がたくさん生えてますね!
これは、「コロニー」と言って菌がたくさん増殖して目に見えるようになった「菌の集落」なんです。
まだ1日しか経ってないのにこんなに沢山の菌が生えてきたという衝撃的な結果!
【培養3日、4日後の様子】
自分4日培養
hさん3日培養
kさん3日培養
tさん3日培養
3日~4日培養するとコロニーがめっちゃ大きく成長しました‼
もともと小さな点だったところが大きく広がったり、
1日後には何も生えていなかった場所に新しいコロニーができたりしていますね。
tさんの培地では、培養1日後には見られなかった黄色のコロニーもありますね!
このように、菌は種類によって増殖する速度や色、形が全然違うのです。
今回の実験では、特にkさんとtさんの手には様々な種類の菌がいることがわかりました。
それに対し、私とhさんの手には同じ種類の菌が沢山いることがわかりました。
4人に共通して、白くて大きく広がったコロニーが見られますが、これはBB菌(バチルス菌)だと考えられます。
他の菌よりも増殖速度が速く、コロニーが大きく広がっているのが特徴です。
また、私の手は研究室の流しで石鹸を使って手を洗った後でしたが、それでもこれだけ菌が生えてきました。
しっかり手洗いをしているつもりでも、完全に手の菌を0個にするのは難しいことが考えられますね…
このように、人や環境によって菌の種類は異なりますが、人の手には何かしらの菌が存在することがわかりました。
2. ペットボトルに口をつけた後、菌が増えるのか?
まず、スーパーでペットボトルのお茶を買い、朝9時過ぎに開封した直後のお茶を培地に塗りました🍵

開封直後のお茶

開封直後のお茶(上から見た写真)
その後、普段通りのペースでお茶を口飲みして、夕方6時半ごろにペットボトル内に残っているお茶を培地に塗りました。

口飲みした後のお茶(上から見た写真)
口飲みした後のお茶の見た目は、開封直後と同じ感じですね。
ちなみに、培地に塗ったお茶の量は0.1 mL(※)です。
※0.1 mLは目薬2滴分くらいのかなり少ない量です。
培地に塗る作業は、他の菌が混入するのを防ぐためにクリーンベンチ(※)の中で行います。
※クリーンベンチの詳しい説明は前回の「微生物アート」のブログをチェック!

クリーンベンチで培地にお茶を塗る様子
また、もしも試験が上手くいかなかったときのために、各条件のお茶を培地2枚ずつに塗りました。
これにより、試験結果の信頼度を上げることができます。
塗り終わったら、30℃に設定した機械の中で菌を培養していきます🦠
【培養1日後の様子】

開封直後のお茶①(1日後)

開封直後のお茶②(1日後)

口飲みした後のお茶①(1日後)

口飲みした後のお茶②(1日後)
開封直後のお茶を塗った培地には何も生えてないですが、
口飲みした後のお茶には白い点々のコロニーが沢山生えてきました!
さらに培養していきます。
【培養4日後の様子】

開封直後のお茶①(4日後)

開封直後のお茶②(4日後)
口飲みした後のお茶①(4日後)

口飲みした後のお茶②(4日後)
1日後と同様、開封直後のお茶は何もないですが、
口飲みした後のお茶はコロニーが大きく育っていました!
それぞれ2枚ずつ塗って2枚とも同じ結果なので、この結果はほぼ正しい結果と言えます。
パッと見た感じ、口飲みした後のお茶のコロニーの数は100個以上は確実にありそうですね。
この培地に塗ったお茶の量は0.1 mLなので、これをペットボトルの総量である650 mLに換算すると…
650000個以上!!!!
開封直後のお茶は菌0個ですが、口飲みして約9時間後のお茶には65万個以上もの菌がいるなんて…
菌の増殖力にもビックリですが、人の口って菌まみれなんですね…
それとも、自分の口が特別汚いのか…?
ちょっと調べてみたところ、
- 大人の口の中には、300~700種類の細菌が生息している
- 歯をよく磨く人で1000~2000億個、あまり歯を磨かない人では4000~6000億個、ほとんど磨かない人では1兆個もの細菌がすみ着いている
という情報がありました。
引用:一般社団法人 日本訪問歯科協会「お口の中は細菌がいっぱい」より
ってことは、口飲みしたペットボトルに65万個以上の菌がいることは妥当なことだろうと思います。
自分の口が特別汚いわけではなさそうで安心しました…(笑)
この検証で、口飲みしたペットボトルの飲み物には、瞬く間に菌が増えるということがわかりました。
特に夏場は菌が活発に働くので、口飲みしたものはその日のうちに飲み干した方が身のためですね。
総括
以上、2つの検証結果から、人の手や口には沢山の菌がいるということがわかりました‼
頭では理解していても、実際に目に見えないと本当に菌がいるかどうかわかりませんが、
今回の検証で菌を「見える化」することができました。
この記事を読んで、身の回りには本当に菌がいるんだ!と感じてもらえたら嬉しいです♬
長くなりましたが、最後まで見てくださりありがとうございました。